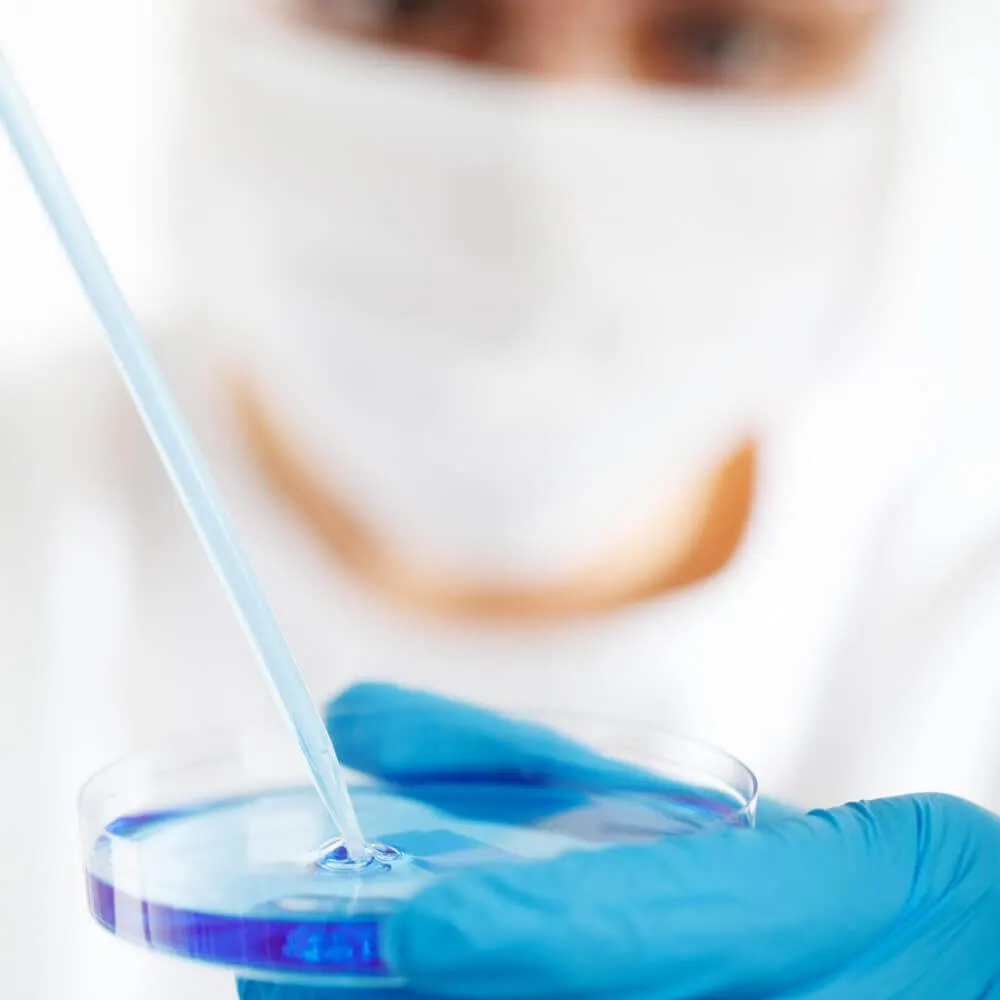
Investigación sobre la diabetes: ¿se avecina una cura?

Investigación sobre la diabetes: futuras terapias
Científicos alrededor del mundo trabajan para facilitar y hacer más efectivo el tratamiento de la diabetes. Simultáneamente, intentan comprender mejor la causa de esta enfermedad.
Aunque algunos enfoques han resultado ser callejones sin salida, otras innovaciones y descubrimientos han llevado a avances. A menudo es difícil prever qué tendrá éxito y qué no. Por ello, el campo sigue siendo emocionante: aquí encontrarás información sobre la investigación en diabetes.
Los investigadores están buscando maneras de mejorar el tratamiento de la diabetes. El profesor Dr. Thomas Forst, del Instituto de Investigación Clínica y Desarrollo en Maguncia, destaca las áreas más significativas: "La investigación en diabetes abarca tres áreas: el desarrollo de nuevos fármacos, nuevas insulinas y el avance hacia sistemas cerrados".
Esto incluye el trasplante de células de los islotes y la bomba de insulina inteligente, capaz de medir independientemente el azúcar en sangre y liberar la dosis adecuada de insulina.


Más que simplemente reducir los niveles de azúcar en sangre
El especialista menciona que los nuevos medicamentos deben no solo disminuir la glucemia, sino también prevenir la hipoglucemia y ayudar con el control del peso.
Los llamados inhibidores de SGLT-2 parecen ofrecer una solución, facilitando la excreción de azúcar a través de los riñones con la orina. Esto no solo reduce el azúcar en la sangre y previene la hipoglucemia, sino que además promueve la pérdida de peso y combate la hipertensión.
El investigador explica que los inhibidores de SGLT-2 reducen la glucosa disponible y, por ende, la energía disponible para el organismo. Como resultado, el paciente baja de peso, lo que es deseado por más del 90% de los diabéticos tipo 2. Dado que la glucosa retiene agua, disminuye también el contenido de líquidos en el paciente. Según Forst, esto reduce la presión arterial de manera similar a ciertos medicamentos. Se estima que los inhibidores de SGLT-2 estarán en el mercado en 2-3 años.
Evitando complicaciones
Forst comenta que las sustancias que actúan sobre el cortisol y mejoran la resistencia a la insulina en la diabetes tardarán más en llegar al mercado. Los activadores de la glucocinasa son muy apreciados entre algunos investigadores.
El experto explica que la enzima glucocinasa se encuentra en las células beta del páncreas y en el hígado. Los activadores de la glucocinasa favorecen la liberación de insulina de las células beta e inhiben la liberación de glucosa del hígado.
Además, los fármacos que combaten la arteriosclerosis, comúnmente asociada con la diabetes, también son importantes. Fort describe que estas sustancias están destinadas a mitigar los efectos secundarios clásicos de la diabetes más que a reducir el azúcar en la sangre.
Suministro de insulina según las necesidades
Una segunda línea de investigación se centra en nuevas insulinas para las formas más comunes de diabetes. Forst subraya el interés en las insulinas inteligentes, que permanecen en el tejido tras la inyección al estar unidas a proteínas. Cuando los niveles de glucosa aumentan, el azúcar libera en parte la insulina de la proteína.
Esto permite que la insulina entre en el torrente sanguíneo y reduzca el azúcar en la sangre. Cuando el nivel de glucosa se normaliza, la liberación de insulina se detiene. Este proceso ha tenido éxito en experimentos con animales, y se espera realizar pruebas en humanos próximamente.


Un para todos
El área de investigación sobre sistemas cerrados abarca prácticas como el trasplante de células de los islotes. Según el experto, este proceso especial busca encapsular las células de los islotes para que el cuerpo no las rechace. Así, no son necesarios inmunosupresores adicionales, que aunque previenen el rechazo, conllevan efectos secundarios.
Además, la bomba de insulina inteligente podría simplificar mucho la vida diaria de los diabéticos al medir el azúcar en sangre de manera independiente y ajustar la dosis de insulina. Sin embargo, Forst advierte que este "sistema" es más complejo de lo que parece y por ahora sigue siendo un sueño a futuro para los pacientes.


El Centro Alemán para la Investigación en Diabetes
La investigación enfoca en desarrollar enfoques individuales para proteger y tratar la diabetes tipo 1 y 2. El DZD trabaja estrechamente y de manera interdisciplinaria combinando la investigación básica y clínica, reuniendo a 180 científicos de renombre en cinco localidades diferentes.
Investigación básica para una mejor comprensión de la diabetes
Para desarrollar estrategias individuales en el manejo de la diabetes, es necesario entender detalladamente la genética y las rutas metabólicas a nivel celular y del organismo. Usando más de 30 modelos de ratones para diabetes, los científicos examinan cambios patológicos en ciertos tejidos y órganos que contribuyen a la enfermedad.
Otros descubrimientos en biología de sistemas proporcionan información sobre cómo factores externos e internos afectan el desarrollo del diabetes. Además, también se emplean elementos epigenéticos para estudiar cómo los factores ambientales impactan los aspectos genéticos.


Investigación sobre células beta, trasplante de islotes e investigación con células madre
Es crucial crear tratamientos para preservar o reconstruir las células beta del páncreas, responsables de la producción de insulina al aumentar los niveles de glucosa en sangre.
Nuevos conocimientos sobre el proceso de secreción de insulina y el hallazgo de sustancias que mejoran la regulación de las células beta podrían ser la base para nuevos medicamentos.
En caso de destrucción irreparable de las células beta, solo un trasplante de páncreas o de células de los islotes podría restablecer la producción de insulina. Estas intervenciones se realizan únicamente en el Instituto Paul Langerhans en Dresde. Los científicos del DZD colaboran estrechamente para mejorar el trasplante de islotes.
La terapia con células madre podría ofrecer una solución alternativa. Investigadores del DZD lideran esta área a nivel nacional y utilizan células madre para estudiar la funcionalidad de las células beta, con el objetivo de desarrollar nuevos medicamentos y lograr un avance en células beta sintéticas.

Investigación y desarrollo de nuevos medicamentos
Para que la terapia de la diabetes sea eficaz y aborde tanto el desarrollo individual como la progresión, es crucial desarrollar nuevas estrategias. Con los avances y la integración de la investigación básica y clínica, progresan la exploración, validación y mejora de nuevos enfoques y sustancias activas.
Impresión de células con biotecnología
En Heidelberg, se imprime tejido productor de insulina usando una bioimpresora 3D. Este avance médico ofrece esperanza a muchas personas con diabetes. Más detalles sobre este desarrollo innovador se encuentran en el sitio web del Ministerio Federal de Educación e Investigación.

